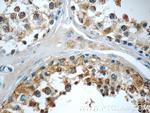
AP2A2 Antibody in Immunohistochemistry (Paraffin) (IHC (P))

Search
Proteintech
AP2A2 Polyclonal Antibody
{{$productOrderCtrl.translations['antibody.pdp.commerceCard.promotion.promotions']}}
{{$productOrderCtrl.translations['antibody.pdp.commerceCard.promotion.viewpromo']}}
{{$productOrderCtrl.translations['antibody.pdp.commerceCard.promotion.promocode']}}: {{promo.promoCode}} {{promo.promoTitle}} {{promo.promoDescription}}. {{$productOrderCtrl.translations['antibody.pdp.commerceCard.promotion.learnmore']}}
产品信息
15722-1-AP
种属反应
宿主/亚型
分类
类型
抗原
偶联物
形式
浓度
规格
纯化类型
保存液
内含物
保存条件
运输条件
产品详细信息
Immunogen sequence: STDILATVL EEMPPFPERE SSILAKLKKK KGPSTVTDLE DTKRDRSVDV NGGPEPAPAS TSAVSTPSPS ADLLGLGAAP PAPAGPPPSS GGSGLLVDVF SDSASVVAPL APGSEDNFAR FVCKNNGVLF ENQLLQIGLK SEFRQNLGRM FIFYGNKTST QFLNFTPTLI CSDDLQPNLN LQTKPVDPTV EGGAQVQQVV NIECVSDFTE APVLNIQFRY GGTFQNVSVQ LPITLNKFFQ PTEMASQDFF QRWKQLSNPQ QEVQNIFKAK HPMDTEVTKA KIIGFGSALL EEVDPNPANF VGAGIIHTKT TQIGCLLRLE PNLQAQMYRL TLRTSKEAVS QRLCELLSAQ F (590-939 aa encoded by BC006155)
靶标信息
Adaptins are components of the adaptor complexes which link clathrin to receptors in coated vesicles. Clathrin-associated protein complexes are believed to interact with the cytoplasmic tails of membrane proteins, leading to their selection and concentration. Alpha adaptin is a subunit of the plasma membrane adaptor. It binds polyphosphoinositides.
仅用于科研。不用于诊断过程。未经明确授权不得转售。
篇参考文献 (0)
生物信息学
蛋白别名: 100 kDa coated vesicle protein C; adapter-related protein complex 2 alpha-2 subunit; adapter-related protein complex 2 subunit alpha-2; adaptin alpha A; Adaptin alpha B; adaptin, alpha B; Adaptor protein complex AP-2 subunit alpha-2; adaptor protein complex AP-2, alpha 2 subunit; adaptor related protein complex 2 alpha 2 subunit; Adaptor-related protein complex 2 subunit alpha-2; adaptor-related protein complex AP-2, alpha 2 subunit; ADTAA; Alpha adaptin A; Alpha adaptin C; Alpha-adaptin C; alpha-adaptin C; Huntingtin interacting protein J; alpha-C adaptin; Alpha1 adaptin; Alpha2 adaptin; Alpha2-adaptin; AP-2 complex subunit alpha-2; AP2 alpha; AP2A1; CLAPA1; Clathrin assembly; Clathrin assembly protein complex 2 alpha-C large chain; clathrin-associated/assembly/adaptor protein, large, alpha 2; HIP 9; HIP-9; Huntingtin yeast partner J; Huntingtin-interacting protein 9; huntingtin-interacting protein HYPJ; Huntingtin-interacting protein J; Plasma membrane adaptor HA2/AP2 adaptin alpha C subunit; unnamed protein product
基因别名: 2410074K14Rik; ADTAB; AF006990; AP2A2; AW146353; C78001; CLAPA2; HIP-9; HIP9; HYPJ; KIAA0899; L25
UniProt ID: (Human) O94973, (Mouse) P17427
Entrez Gene ID: (Human) 161, (Rat) 81637, (Mouse) 11772